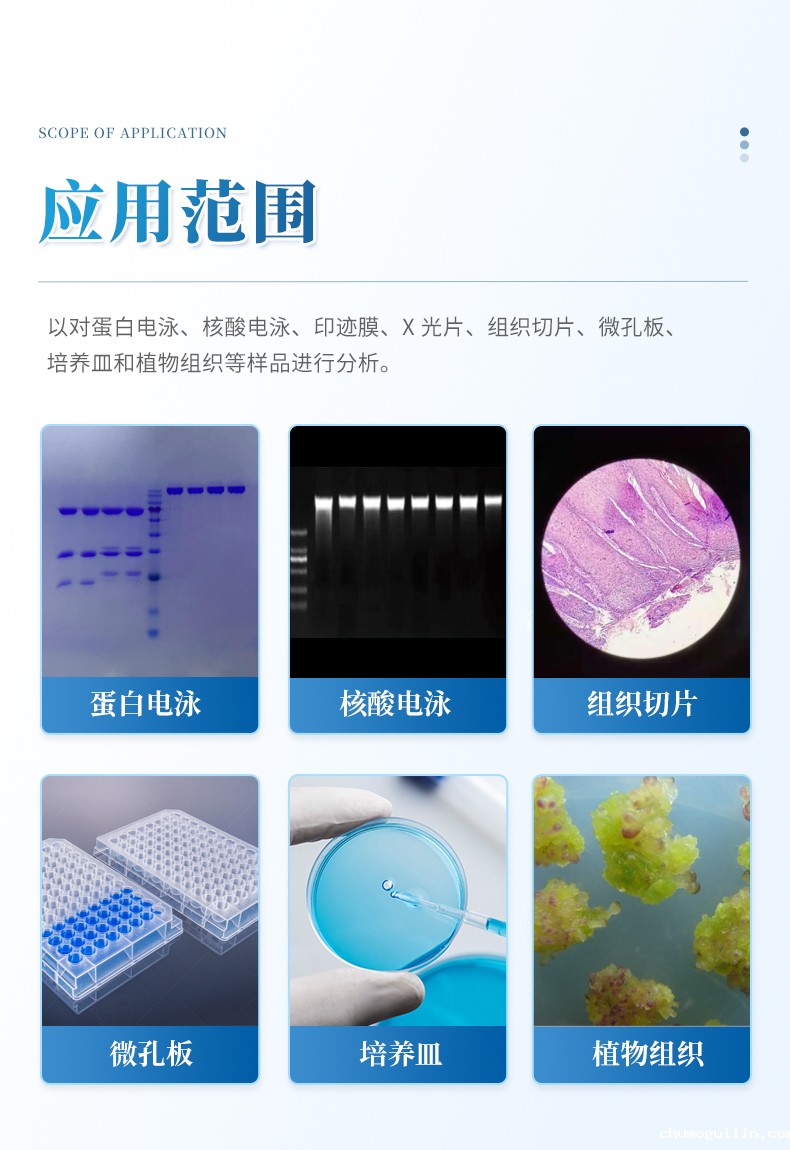
详情_03

免费的足球直播网站
联系人:李经理
销售电话:19157135090
销售QQ:858406657
公司地址:山东省潍坊市高新区欧龙科技园三号车间

联系人:李经理
销售电话:19157135090
销售QQ:858406657
公司地址:山东省潍坊市高新区欧龙科技园三号车间

免费的足球直播网站专注于化学发光成像仪的研发与生产,提供化学发光成像仪的定制服务,化学发光成像仪型号齐全,检测精度高,深受客户信赖!

超敏化学发光成像系统,标配化学发光成像,彩色marker 自动整合功能,凝胶成像及白 光、蓝光成像。可以对蛋白电泳、核酸电泳、印迹膜、X 光片、组织切片、微孔板、培养 皿和植物组织等样品进行全自动图像采集并进行定性和定量分析。
1、化学发光彩色 marker 自动整合

2、植物自发光成像

3、凝胶成像凝胶成像功能(可以进行伪彩标记)

4、精确定量分析:
对 1ng 的 NIH 细胞裂解物进行二倍稀释,用 WB 方 法检 测 ERK 蛋白,使用 Image600 进行化学发光检测, 检测下限可 达 5.2pg 。
不低于 4.8 的超大宽动态范围可以同时检测强弱条带信号,并且可通过不同的 binning 值提高相机灵敏度,从而满足用户对不同弱信号条带的曝光需求

1. 光子级成像,信号无遗漏
比传统设备更快、更灵敏,让弱信号无处可藏
采用独特的光子级成像技术、超低降噪处理技术,结合大耙面背照式超敏检测器以及大通 光透镜,使得极微弱信号捕捉变的更容易。灵敏度远超同类产品,成像效果更好,采集速 度提升 2-3 倍(原需 2 分钟,现仅 40-60 秒),避免科研成果错失。我司研发的新一代 超敏化学发光成像系统完全可替代进口同类产品。
2. 超大检测器,灵敏度再升级
大尺寸芯片,领先行业标准,信号捕捉更容易
Image600 搭载 1.1 英寸背照式超敏检测器,灵敏度大幅提升,轻松应对极微弱信号挑战
3. 采用大口径 0.95 镜头,通光量倍增
光圈优势,让暗处细节一目了然,优于常规镜头
采用 F0.95(可选配 F0.8 )超大光圈高透镜头,通光量显著增大,配合 1.1 英寸大尺寸芯 片,使得弱信号不无处可藏。
4. 智能对焦,省时高效
自动化操作,对焦时间仅需 1-2S,提升实验效率。
高速对焦电机实现快速自动对焦,无需人工干预,快速获取清晰图像。
5. 一键曝光,智能优化
傻瓜式操作,比复杂设置更便捷,结果更可靠。
一键自动曝光功能,智能适配样品发光强度,确保高质量成像。
6. 彩色 Marker,自动合成
让未知蛋白判断更直观;简化流程,告别手动合成,效率翻倍
自动彩色 marker 合成,无需操作者进行复杂的调整,即可生成最佳的彩色 marker 合成图 像。
7. AI 图片命名,智能便捷
智能命名,比传统方式更高效,减少人为错误
一键进行图片命名,仅需对同组图片中任意一张进行命名,一键 AI 自动生成其它图片名 称。
8. 灵活保存,操作直观
用户友好设计,比繁琐保存更灵活,提升工作效率
图片保存,可支持任意勾选单张或多张图片进行保存,界面操作简单且直观易用。
9. 数据溯源,信息完整
内置溯源功能,确保数据可信,优于基础记录
每张图像都带有图像信息,如:图片采集时间、图片生成日期、图片采集时的曝光参数条 件、及使用人员的信息等,方便后期进行数据朔源。
10. 一键伪彩,信号强度可视化
快速可视化,让分析更直观,实验决策更精准。
一键伪彩染色,可以简单直观了解信号强弱分布情况。
市场同类产品对比,为何选择我们?
产品迭代,
不只是升级而是革命——以国产替代进口性能,提供更高性价 比。
>速度与灵敏度双赢 >自动化智能操作
>质保期长,终身免费享受软件更新服务 >高价比高
>配置灵活,并提供专业化订制服务
技术先进性:采用光子级成像技术,大大提高了检测速度及灵敏度, ECL 检测性能更是完 美超越
一键自动化智能检测:无需客户过多的设置,一键即可采集到最佳图片信息,并实现自动 图片灰度压缩及合成,从而完美展现信号可视化效果。
质保及服务:整机质保期 3 年,终身免费享受软件更新服务,给您带来不一样的服务体 验。
高性价比:ECL 性能更是优于进口品牌,且价格只有进口品牌一半不到。
配置灵活:我司提供高中低多种型号可选,并支持用户订制的特殊服务,如支持订制特殊 的激发波长及发射波长,以适应特殊的荧光染料需求。
采用 13.3 寸触摸屏控制,内存 16G,256G 固态硬盘,使仪器具有更强大图像计算及 处理能力,配合图像采集软件操作简捷直观,软件具有自动采集信号及彩色 marker,并进 行自己处理合成功能;曝光模式分为自动曝光、手动曝光、累积曝光、总累积曝光以及自 动定义曝光功能。配合图像分析软件可对图像信号进行定性定量分析。
相机:采用背照式超敏检测器, 1 英寸大耙面芯片检测器
动态范围: ≥4.8 个数量级
数据位数:16bit
镜头:采用微距大口径 F0.95(可选 配 F0.8 高透镜头)镜头,进光量大,曝光速 度快
制冷温度:低于环境温度 45℃,制冷速度快 2-3 分钟即可
Binning 模式:像素合并:1×1, 2×2, 3×3 4×4, 5×5,6×6, 8×8, 16× 16
样品板尺寸:>20*18cm
滤光片轮:8 位,标配595nm 滤光片,透过率 90%以上
激发光源 ●反射白光 ●透射 UV365nm(302nm 、254nm 选配) ●反射 RGB O 透射蓝光选配
软件功能:
图像采集软件可自动变焦,聚焦,无需手动,可实现一键拍照。
图像采集软件具有单张自动曝光功能,根据样品发光强度自动选择合适的曝光 时间。
图像采集软件具有累积曝光和多张曝光功能,可根据实验需求自由选择。
图像采集软件支持正反色显示功能,可根据需要进行切换。
图像采集软件支持过曝提示功能,在拍摄结果中显示过曝像素,保证定量精 确。
图像采集软件可对图像进行裁剪、旋转等操作。
图像采集软件可进行信号伪彩染色及合成等操作。
图像保存,同组图片只需任意命其中一图片,即可一键生成同组图片命名,操 作简单方便。
软件具有相机保护功能,退出软件相机会自动进入保护状态




